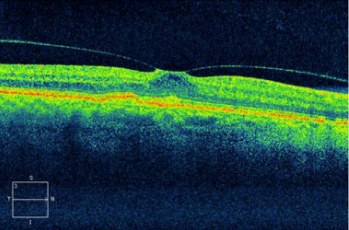
这是炎症影响视网膜表面的结果,形成原因可能是:炎症致玻璃体浓缩

视网膜牵拉

复杂视网膜脱落病例使用气体填充失败后,或视网膜存在牵拉因素(例如
图片尺寸363x275
渗出性视网膜脱离和牵拉性视网膜脱离,其中孔源性视网膜脱离是由于
图片尺寸6036x3700
玻璃体视网膜交界面疾病
图片尺寸2667x2000
【求助】玻璃体黄斑牵拉综合征
图片尺寸2448x3264
眼底出血,玻璃体积血的患者,出血后造成机化条索反复牵拉视网膜造成
图片尺寸478x336
视盘附近围绕弧形的牵拉痕迹.视网膜非常薄了.
图片尺寸2048x1536
以防进一步发生玻璃体积血,视网膜增殖膜和牵拉性视网膜脱离等
图片尺寸570x435
收缩,并进一步引起牵拉性视网膜脱离和失明
图片尺寸569x800
正常外界的光线透过眼前部到达眼底视网膜上,形成清晰的视力.
图片尺寸750x482
视网膜脱离的概述
图片尺寸1280x1280
一个裂孔变成两个裂孔,再一步牵拉导致视网膜脱离(简称"网脱")
图片尺寸901x902
眼轴变长后,玻璃体就会牵拉视网膜,形成视网膜裂孔,液化的玻璃体经裂
图片尺寸1080x810
"手动40cm,视物非常差了","双眼玻璃体混浊,其中左眼整个视网膜都脱离
图片尺寸640x532
增生性糖尿病视网膜病变Ⅵ期图中显示视乳头前机化牵拉性视网膜脱离
图片尺寸502x381
关于视网膜这些知识我们必须知道
图片尺寸1800x1200
惊年前大扫除长沙阿姨用力过度竟导致视网膜脱离
图片尺寸1134x851
视网膜脱离病因及治疗方法_视网膜脱落_发病原因_治疗方式 - 好大夫
图片尺寸582x418
这是炎症影响视网膜表面的结果,形成原因可能是:炎症致玻璃体浓缩
图片尺寸349x230
对中高度近视伴周边视网膜裂孔,变性和玻璃体牵拉,或对侧眼已经出现
图片尺寸3988x2991
玻璃体黄斑牵拉一例自行恢复实属万幸
图片尺寸878x640